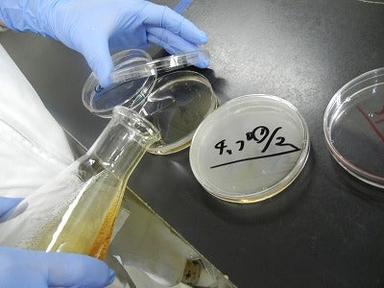
画像

全国生コンクリート工業組合連合会 中央技術研究所
【時給1500円◎週3~OK!】未経験歓迎の実験作業補助のお仕事♪時給1,500円~
詳細
- |勤務・面接|千葉県船橋市 / 南船橋駅(徒歩15分)

※平均時給の情報は、2025年11月に求人情報サイト「バイトル」に掲載された、雇用形態が「アルバイト」または「パート」で、給与が時給制の仕事情報をもとに算出しています。なお、ディップ株式会社が毎月発表しているアルバイト平均時給調査とは算出している仕事情報が一部異なります。
検査(千葉県)のアルバイト・パートの平均時給は1,450円です。
今月、検査(千葉県)がバイトルに掲載された数は680件でした。
11月の平均時給は、前月と比較して9円上昇しました。
また、昨年の11月と比較して240円上昇しました。
線グラフ:平均時給(円)
棒グラフ:求人数
千葉県で、検査のお仕事に興味がある方は、時給以外に以下の条件も合わせて検索しています。
千葉県で、検査に関連した他の職種は、玉掛けで平均時給が1,800円、ライン作業で平均時給が1,663円、半導体・電子部品製造で平均時給が1,523円となっています。
関東の都道府県ごとでの、検査の平均時給はこちら。

全国生コンクリート工業組合連合会 中央技術研究所
【時給1500円◎週3~OK!】未経験歓迎の実験作業補助のお仕事♪時給1,500円~

株式会社スマートコミュニケーションズ
\週3日~OK/未経験活躍中★座ってできる検査業務!日払いOK♪時給1,400円~

株式会社バイトレ
短期&単発★1日でできる軽作業バイト☆好きな時にシフトIN★時給1,400円~

株式会社バイトレ
週0でもOK!?自由すぎる日払いバイト♪アナタの為の職場ココに★時給1,301円~

株式会社バイトレ
単発/短期/週0~…etc 働き方は人それぞれ!日払いOK&履歴書不要時給1,260円~

株式会社バイトレ
短期集中で爆稼ぎ★日払い軽作業ワーク★稼げるにぜん集中!!時給1,400円~
旭化工株式会社 東金工場
【週2日~&賞与年2回】エアコン完備の室内作業◎軽作業staff♪時給1,140円~
豊橋飼料株式会社
\データ入力&梱包作業/週3/4h~|精用資材のカンタン作製作業時給1,200円~

旭化工株式会社 東金工場
【1日2h~&週1日~】新工場完成に向け軽作業staff10名募集♪時給1,140円~
ライフ 船橋プロセスセンター
【衛生管理スタッフ】未経験歓迎/交通費支給◎時給1,150円~
アルバイト・バイト求人を
他の方法で探す
他のエリアや職種の平均時給を見る